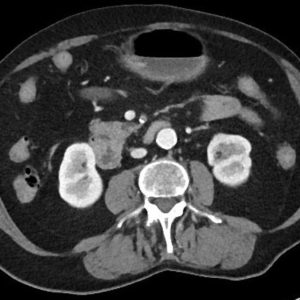
Huyết khối động mạch MTTT

TIÊU HOÁ
Hiển thị 1081–1100 của 1445 kết quảĐã sắp xếp theo mới nhất
-

Thoát vị hoành
Lượt xem: 1196» 19-12-2018 -

Thoát vị hoành
Lượt xem: 1134» 16-12-2018 -

Thoát vị hoành
Lượt xem: 5» 14-12-2018 -

Lồng ruột
Lượt xem: 201» 13-12-2018 -

Huyết khối động mạch MTTT
Lượt xem: 1092» 12-12-2018 -

Nhồi máu ruột
Lượt xem: 198» 12-12-2018 -

Huyết khối động mạch MTTT
Lượt xem: 1080» 12-12-2018 -

Huyết khối động mạch MTTT
Lượt xem: 1049» 12-12-2018 -

Huyết khối động mạch MTTT
Lượt xem: 1066» 12-12-2018 -

Huyết khối tĩnh mạch MTTT
Lượt xem: 15305» 12-12-2018 -

Huyết khối tĩnh mạch MTTT
Lượt xem: 309» 12-12-2018 -

Huyết khối tĩnh mạch MTTT
Lượt xem: 278» 12-12-2018 -

Huyết khối tĩnh mạch MTTT
Lượt xem: 286» 12-12-2018 -

Huyết khối tĩnh mạch MTTT
Lượt xem: 263» 12-12-2018 -

Huyết khối tĩnh mạch MTTT
Lượt xem: 324» 12-12-2018 -

U ruột non
Lượt xem: 304» 12-12-2018 -

Thoát vị hoành
Lượt xem: 265» 10-12-2018 -

Thoát vị De Garengeot
Lượt xem: 338» 10-12-2018 -

Xoắn dạ dày
Lượt xem: 354» 10-12-2018 -

Túi thừa thực quản
Lượt xem: 371» 09-12-2018